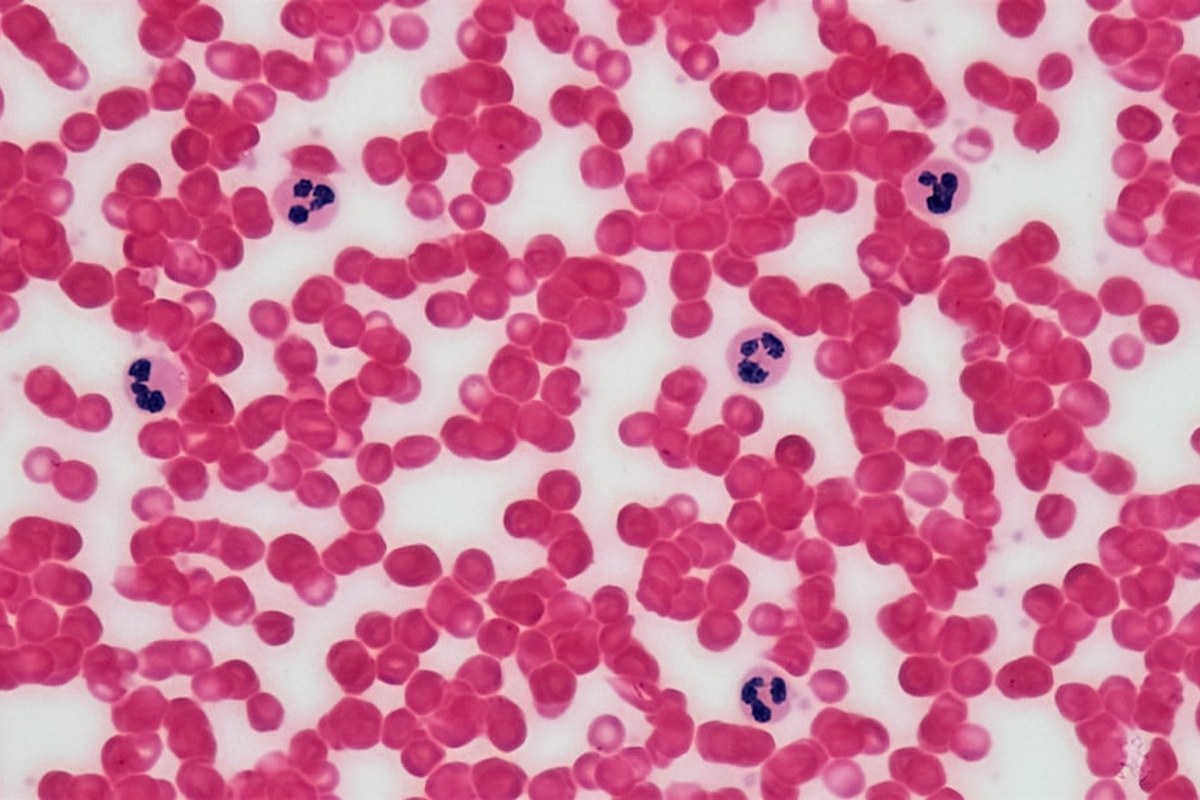
🚨 빈혈, 단순 피로 NO! 치매 위험 66% UP! 뇌 건강 적신호 💡 - 이미지 3

์ ๋ชฉ (3๊ฐ์ง)
- ๐จ ๋นํ, ๋จ์ ํผ๋ก NO! ์น๋งค ์ํ 66% UP! ๋ ๊ฑด๊ฐ ์ ์ ํธ ๐ก
- “์ด์ง๋ผ์ฆ ๋์ด ์น๋งค๊น์ง?” ๋นํ, ๋น์ ์ ๋๋ฅผ ์ํํ๋ ์ง์ง ์ด์
- ๋นํ ๋ฐฉ์นํ๋ฉด ์น๋งค ์ํ โโฆ ๋ ๊ฑด๊ฐ ์งํค๋ ๋๋ํ ๊ด๋ฆฌ๋ฒ
๋นํ, ๋จ์ ํผ๋ก๊ฐ ์๋๋ค? ๋ ๊ฑด๊ฐ์ ์จ๊ฒจ์ง ์ํ โ ๏ธ
“๋นํ์ ๋จ์ํ ํผ๋ก ๋ฌธ์ ๊ฐ ์๋๋ผ, ์น๋งค ์ํ์ ์ต๋ 66%๊น์ง ๋์ผ ์ ์์ต๋๋ค.”
ํน์ ์ต๊ทผ ๋ค์ด ๋ถ์ฉ ํผ๊ณคํ๊ณ ์ด์ง๋ผ์ฆ์ ์์ฃผ ๋๋ผ์๋์? ๋จ์ํ ์ ์ด ๋ถ์กฑํ๊ฑฐ๋ ์คํธ๋ ์ค ๋๋ฌธ์ด๋ผ๊ณ ์๊ฐํ๋ค๋ฉด, ์ด์ ๋ ๋นํ์ ์์ฌํด ๋ด์ผ ํ ๋์ ๋๋ค. ๋นํ์ ์ฐ๋ฆฌ ๋ชธ ๊ณณ๊ณณ์ ์ฐ์๋ฅผ ๊ณต๊ธํ๋ ์ ํ๊ตฌ๋ ํค๋ชจ๊ธ๋ก๋น์ด ๋ถ์กฑํด ๋ฐ์ํ๋ ์ํ๋ก, ๋จ์ํ ๋ถํธํจ์ ๋์ด ์ฌ๊ฐํ ๋ ๊ฑด๊ฐ ๋ฌธ์ ์๋ ์ฐ๊ฒฐ๋ ์ ์๋ค๋ ์ฐ๊ตฌ ๊ฒฐ๊ณผ๊ฐ ๋์์ต๋๋ค.
๋นํ, ์น๋งค์ ์ด๋ค ๊ด๊ณ๊ฐ ์์๊น? ๐ง
์ค์จ๋ด๊ณผ ์ดํ๋ฆฌ์ ์ฐ๊ตฌ์ง์ด 60์ธ ์ด์ ์ฑ์ธ 2282๋ช ์ ๋์์ผ๋ก ์งํํ ์ฅ๊ธฐ ์ถ์ ์ฐ๊ตฌ๋ ๋นํ๊ณผ ์น๋งค์ ๋๋ผ์ด ์ฐ๊ด์ฑ์ ๋ฐํ๋์ต๋๋ค. ํ๊ท 9.3๋ ์ ์ถ์ ๊ธฐ๊ฐ ๋์, ์ฐ๊ตฌ ์์ ์์ ์ ๋นํ์ด ์์๋ ์ฌ๋๋ค์ ๊ทธ๋ ์ง ์์ ์ฌ๋๋ค์ ๋นํด ์น๋งค ๋ฐ์ ์ํ์ด ๋ฌด๋ ค 66% ๋ ๋์์ต๋๋ค.
ํค๋ชจ๊ธ๋ก๋น ์์น๊ฐ ๋ฎ์์๋ก ์์ธ ํ์ด๋จธ๋ณ๊ณผ ๊ด๋ จ๋ ํ์ก ์์ฒด์งํ ์์น๊ฐ ๋์ ๊ฒฝํฅ์ด ํ์ธ๋์์ต๋๋ค. ์ด๋ ๋์ธํฌ ์์ ๋ฐ ์ผ์ฆ๊ณผ ๊ด๋ จ์ด ์์ต๋๋ค.
์ด๋ฌํ ์ฐ๊ด์ฑ์ ํนํ ๋จ์ฑ์๊ฒ์ ๋ ๊ฐํ๊ฒ ๋ํ๋ฌ์ต๋๋ค. ๋นํ์ด ๋๋ก ๊ฐ๋ ์ฐ์ ๊ณต๊ธ์ ์ค์ฌ ๋์ธํฌ์ ์ง์์ ์ธ ์คํธ๋ ์ค๋ฅผ ์ฃผ๊ณ , ๊ฒฐ๊ตญ ํ๊ด ์์๊ณผ ์ ๊ฒฝ์ธํฌ ์์ค์ ์ ๋ฐํ ์ ์๋ค๋ ๊ฒ์ด ์ ๋ ฅํ ์ค๋ช ์ ๋๋ค.

๋นํ๊ณผ ์น๋งค ์ํ: ์ฃผ์ ์ฐ๊ตฌ ๊ฒฐ๊ณผ ์์ฝ
| ๊ตฌ๋ถ | ๋ด์ฉ |
|---|---|
| ์ฐ๊ตฌ ๋์ | 60์ธ ์ด์, ์น๋งค ์๋ ์ฑ์ธ 2282๋ช (์ค์จ๋ด) |
| ์ถ์ ๊ธฐ๊ฐ | ํ๊ท 9.3๋ |
| ์น๋งค ์ง๋จ์ | ์ด 362๋ช |
| ๋นํ๊ณผ ์น๋งค ์ํ | ๋นํ ํ์, ์น๋งค ์ํ 66% ์ฆ๊ฐ |
| ๋จ๋ ์ฐจ์ด | ๋จ์ฑ์๊ฒ์ ์ฐ๊ด์ฑ ๋ ๊ฐํ๊ฒ ๋ํ๋จ |
| ๊ด๋ จ ์งํ | ํค๋ชจ๊ธ๋ก๋น ์์น ๋ฎ์์๋ก ๋ ์์/์ผ์ฆ ๊ด๋ จ ์งํ ๋์ |
๋นํ, ๋ ์์์ ์ด๊ธฐ ์ ํธ์ผ ์ ์๋ค? ๐ก
๋นํ์ด ๋จ์ํ ์น๋งค ์ํ์ ๋์ด๋ ๊ฒ์ ๋์ด, ๋ ์์์ ์ด๊ธฐ ์ ํธ์๋ ๊ด๋ จ์ด ๊น๋ค๋ ์ฐ๊ตฌ ๊ฒฐ๊ณผ๋ ์์ต๋๋ค. ํนํ ๋นํ๊ณผ ํจ๊ป ํน์ ๋จ๋ฐฑ์ง ์์น๊ฐ ๋์ ๋ ์น๋งค ์ํ์ ๋์ฑ ์ปค์ก์ต๋๋ค.
๋นํ์ด ์์ผ๋ฉด์ ์ ๊ฒฝ์ธํฌ ์์ ์งํ(NfL) ์์น๊ฐ ๋์ ์ฌ๋์ ์น๋งค ๋ฐ์ ์ํ์ด 3.5๋ฐฐ ๋๊ฒ ๋ํ๋ฌ์ต๋๋ค.
์ด๋ ๋นํ์ด ๋๋ฅผ ๋์ฑ ์ทจ์ฝํ๊ฒ ๋ง๋ค์ด, ์น๋งค ์ฆ์์ด ๋ ๋นจ๋ฆฌ ๋ํ๋๊ฑฐ๋ ์ด๋ฏธ ๋ ์์์ด ์๋ ์ํ์์ ์น๋งค๊ฐ ๋ ๋น ๋ฅด๊ฒ ์งํ๋ ์ ์์์ ์์ฌํฉ๋๋ค. ์ฐ๊ตฌ์ง์ ๋นํ์ด ์น๋งค ์ํ ํ๊ฐ์ ์ค์ํ ์์๊ฐ ๋ ์ ์์ผ๋ฉฐ, ์์ธ ํ์ด๋จธ๋ณ ์๋ฐฉ์ ์ํ ์ ์ฌ์ ๊ด๋ฆฌ ๋์์ด ๋ ์ ์๋ค๊ณ ์ ์ํ์ต๋๋ค.

๋นํ, ์ด๋ป๊ฒ ๊ด๋ฆฌํด์ผ ํ ๊น? โ
๋นํ์ ๊ฐ์ฅ ํํ ์์ธ์ ์ฒ ๋ถ ๋ถ์กฑ์ ๋๋ค. ์ฒ ๋ถ์ ์ฐ๋ฆฌ ๋ชธ์ ๊ผญ ํ์ํ ์์์์ด๋ฉฐ, ์์์ ํตํด ์ถฉ๋ถํ ๋ณด์ถฉํ ์ ์์ต๋๋ค.
๋นํ ์๋ฐฉ ๋ฐ ๊ด๋ฆฌ๋ฅผ ์ํ ์๋จ ๐
- ์ฒ ๋ถ ํ๋ถ ์ํ: ๋ถ์ ์ด์ฝ๊ธฐ, ๊ฐ, ๋ฌ๊ฑ ๋ ธ๋ฅธ์, ๊ตด, ๋๋ถ, ์ฝฉ๋ฅ, ๋ น์ ์ฑ์, ํด์กฐ๋ฅ
- ํก์์จ ๋์ด๊ธฐ: ์๋ฌผ์ฑ ์ํ ์ญ์ทจ ์ ๋นํ๋ฏผ C๊ฐ ํ๋ถํ ๊ณผ์ผ, ์ฑ์์ ํจ๊ป ์ญ์ทจ (์: ์๊ธ์น + ์ค๋ ์ง ์ฃผ์ค)
- ๊ธฐํ ์์์: ๋นํ๋ฏผ B12 (๋๋ฌผ์ฑ ์ํ), ์ฝ์ฐ (์จ์, ๋ ์ฝฉ, ์๊ธ์น, ์ฐ์ด)
๋ค๋ง, ๋นํ์ด ๋ค๋ฅธ ์งํ์ ์ํด ๋ฐ์ํ ๊ฒฝ์ฐ ์์ด ์กฐ์ ๋ง์ผ๋ก๋ ๋ถ์กฑํ ์ ์์ต๋๋ค. ๋ฐ๋์ ์ ๋ฌธ๊ฐ์ ์๋ดํ์ฌ ์ ํํ ์์ธ์ ์ง๋จ๋ฐ๊ณ ์ ์ ํ ์น๋ฃ๋ฅผ ๋ณํํด์ผ ํฉ๋๋ค.
๋นํ, ์น๋งค ์๋ฐฉ์ ์ํ ์ฒซ๊ฑธ์ ๐ถโโ๏ธ๐ถโโ๏ธ
๋นํ์ ๋จ์ํ ํผ๋ก๊ฐ์ผ๋ก ๋๊ธธ ๊ฒ์ด ์๋๋ผ, ๋ ๊ฑด๊ฐ์ ์ํํ๋ ์ค์ํ ์ ํธ์ผ ์ ์์ต๋๋ค. ํนํ ๊ณ ๋ น์ธต์์ ๋นํ์ ์น๋งค ์ํ์ ๋์ด๋ ์์ธ์ผ๋ก ์์ฉํ ์ ์์ผ๋ฏ๋ก, ํ์ ์์ ์ ๊ฑด๊ฐ ์ํ๋ฅผ ์ฃผ์ ๊น๊ฒ ์ดํผ๋ ๊ฒ์ด ์ค์ํฉ๋๋ค.
๋นํ์ ์กฐ๊ธฐ์ ๋ฐ๊ฒฌํ๊ณ ์ ๊ทน์ ์ผ๋ก ๊ด๋ฆฌํ๋ ๊ฒ์ด ์ฅ๊ธฐ์ ์ธ ๋ ๊ฑด๊ฐ์ ์งํค๋ ํ๋ช ํ ๋ฐฉ๋ฒ์ด ๋ ์ ์์ต๋๋ค.
๋ฌผ๋ก ๋นํ์ ์น๋ฃํ๋ค๊ณ ํด์ ์น๋งค๊ฐ 100% ์๋ฐฉ๋๋ ๊ฒ์ ์๋๋๋ค. ํ์ง๋ง ๋๋ฅผ ๋์ฑ ํผํผํ๊ฒ ๋ง๋ค์ด ์ธ์ง ๊ธฐ๋ฅ ์ ํ๋ฅผ ๋ฆ์ถ๊ณ , ์ ๋ฐ์ ์ธ ๊ฑด๊ฐ์ ๊ฐ์ ํ๋ ๋ฐ ๋ถ๋ช ๋์์ด ๋ ๊ฒ์ ๋๋ค.
์์ฃผ ๋ฌป๋ ์ง๋ฌธ (FAQ)
๋นํ์ด ์์ผ๋ฉด ๋ฌด์กฐ๊ฑด ์น๋งค์ ๊ฑธ๋ฆฌ๋์?
์๋๋๋ค. ๋นํ์ด ์น๋งค ์ํ์ ๋์ด๋ ‘์ํ ์์ธ’ ์ค ํ๋๋ก ๋ฐํ์ก์ง๋ง, ๋นํ์ด ์๋ค๊ณ ํด์ ๋ฐ๋์ ์น๋งค์ ๊ฑธ๋ฆฌ๋ ๊ฒ์ ์๋๋๋ค. ํ์ง๋ง ๋นํ์ ๋ฐฉ์นํ๋ฉด ๋ ๊ฑด๊ฐ์ ์ข์ง ์์ ์ํฅ์ ์ค ์ ์์ผ๋ฏ๋ก, ์ ๊ทน์ ์ธ ๊ด๋ฆฌ์ ์น๋ฃ๊ฐ ์ค์ํฉ๋๋ค.
๋นํ ๊ฒ์ฌ๋ ์ด๋ป๊ฒ ํ๋์?
๊ฐ์ฅ ๊ธฐ๋ณธ์ ์ธ ๋นํ ๊ฒ์ฌ๋ ํ์ก ๊ฒ์ฌ๋ฅผ ํตํด ์ ํ๊ตฌ ์, ํค๋ชจ๊ธ๋ก๋น ์์น, ํค๋งํ ํฌ๋ฆฟ ์์น ๋ฑ์ ์ธก์ ํ๋ ๊ฒ์ ๋๋ค. ํ์์ ๋ฐ๋ผ ์ฒ ๋ถ ์์น, ๋นํ๋ฏผ B12, ์ฝ์ฐ ์์น ๋ฑ์ ์ถ๊ฐ๋ก ๊ฒ์ฌํ ์ ์์ต๋๋ค.
๋นํ ์น๋ฃ๋ ์ด๋ป๊ฒ ์ด๋ฃจ์ด์ง๋์?
๋นํ์ ์์ธ์ ๋ฐ๋ผ ์น๋ฃ ๋ฐฉ๋ฒ์ด ๋ฌ๋ผ์ง๋๋ค. ๊ฐ์ฅ ํํ ์ฒ ๊ฒฐํ์ฑ ๋นํ์ ๊ฒฝ์ฐ ์ฒ ๋ถ ๋ณด์ถฉ์ ๋ณต์ฉ์ด๋ ์ฒ ๋ถ์ด ํ๋ถํ ์๋จ ์ญ์ทจ๊ฐ ๋์์ด ๋ฉ๋๋ค. ๋นํ๋ฏผ B12๋ ์ฝ์ฐ ๋ถ์กฑ์ผ๋ก ์ธํ ๋นํ์ ํด๋น ์์์๋ฅผ ๋ณด์ถฉํ๋ ์น๋ฃ๋ฅผ ๋ฐ๊ฒ ๋ฉ๋๋ค. ๋ค๋ฅธ ์งํ์ด ์์ธ์ธ ๊ฒฝ์ฐ, ํด๋น ์งํ์ ๋จผ์ ์น๋ฃํ๋ ๊ฒ์ด ์ค์ํฉ๋๋ค.
์ด ์ ๋ณด๋ ์ํ์ ์ง๋จ์ ๋์ฒดํ ์ ์์ต๋๋ค.

๋๊ธ์ ๋ซํ ์์ง๋ง, trackbacks ๋ฐ ํ๋ฐฑ์ ์ด๋ ค ์์ต๋๋ค.